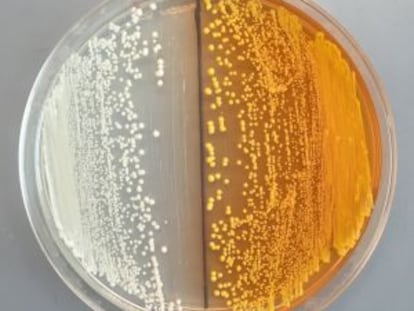

Se busca veneno que cure
Un consorcio europeo extrae 5.700 proteínas de ponzoñas de 203 animales El objetivo es dar con moléculas con propiedades terapéuticas que se puedan convertir en medicamentos

Un consorcio europeo extrae 5.700 proteínas de ponzoñas de 203 animales El objetivo es dar con moléculas con propiedades terapéuticas que se puedan convertir en medicamentos

La transexual Martine Rothblatt es la ejecutiva mejor pagada, y una visionaria de la medicina, la inteligencia artificial o las telecomunicaciones. Esta es su historia

La Guardia Civil interviene más de un millón de medicamentos ilegales en el marco de la Operación Pangea

Casi todo el país se encuentra bajo aviso porque el termómetro rondará los 40 grados

L’Administració els deu la factura dels medicaments que van dispensar a l’abril i al maig

La Administración les debe la factura de los medicamentos que dispensaron en abril y mayo
La policía implica a 11 personas; el negocio funcionaba las 24 horas en la Costa del Sol
El grupo químico impulsa su presencia en el extranjero con adquisiones en América Latina

La combinación de ambos productos permite tratamientos dirigidos más potentes y con menos efectos secundarios

El nen no vacunat que pateix la malaltia infecciosa segueix "estable dins de l'extrema gravetat"

El niño no vacunado que padece la enfermedad infecciosa sigue "estable dentro de la extrema gravedad"

La estadounidense Julie Hamp recibió un paquete por correo con 57 pastillas
La fiscalía pide seis años para un médico del hospital de La Princesa acusado de estafa y falsedad por recetar medicamentos que luego revendía
El atleta italiano se preparara para la cita de Rio 2016 trabajando en un carril bici de la capital italiana

El atleta italiano, oro olímpico de marcha en Pekín que lleva casi tres años sancionado por EPO, busca redimirse trabajando con el icono de la lucha antidopaje y del deporte limpio

Estar bronceado resulta atractivo, pero también es peligroso. Arrugas, manchas, melanomas y carcinomas son las consecuencias más dañinas

La Generalitat acumula un retard de dos mesos en el pagament dels fàrmacs
La Generalitat acumula un retraso de dos meses en el pago de los fármacos dispensados por las boticas

La farmacéutica Bagó, fundada en 1934, opera en toda la región salvo en Venezuela
Encontrar una solución a los microbios resistentes exige inversiones en el desarrollo de nuevas medicinas y un sistema de control mejor para preservar su eficacia
La FDA recibe luz verde para comercializar una píldora que incrementa el deseo sexual

Víctor Grífols, president d’honor de la companyia, mor als 95 anys

Víctor Grifols, expresidente de la compañía, muere a los 95 años

La farmacéutica española llega a un acuerdo con la china Eddingpharm para la constitución de una compañía conjunta

Más de 200.000 personas tienen esta enfermedad inflamatoria en España

Unas dos mil boticas exigen más de 22 millones por las demoras en el abono de facturas de medicamentos desde 2011

La plataforma SCReN realiza comparaciones entre fármacos o cirugías, estrategias sin interés comercial pero con muchos beneficios para los pacientes y la Administración
La farmacéutica factura más de 120 millones de euros y potencia su área de autocuidado

Desde el momento en que encontrará menos gente al significado de las claves de su receta. Desvelamos los pequeños secretos del local de la cruz verde

Diseñado un método rompedor contra la resistencia a los antibióticos Está basado en fagos, unos virus que atacan a las bacterias
Un equipo de científicos consigue dar el último paso hacia un microbio que fabrique morfina y otros opiáceos Expertos alertan de que será muy fácil fermentar estupefacientes

Una nueva familia de fármacos ayuda a controlar el azúcar y, a la vez, bajan la tensión y el peso

Un informe denuncia que las comunidades endurecen los requisitos de las guías terapéuticas para no darles los fármacos más modernos -y caros-

Un protector estomacal, un analgésico y un reductor de colesterol son los fármacos más vendidos en España según Sanidad. Los expertos advierten contra su uso sin prescripción médica

Un cardiólogo cuenta cómo su paciente tuvo dos infartos por no poder pagar la medicación

El Ministerio de Sanidad pregunta por primera vez si se ha dejado de tomar un fármaco recetado por el médico por ser caro
El mundo vegetal está lleno de maravillas como esta, una planta con que fabricar su propio ungüento antimoratones
La belga Ecuphar adquiere el negocio, que factura 33 millones, y asumirá 95 trabajadores

L'empresa farmacèutica no va notificar la concentració en la compra d'actius de Novartis

La empresa farmacéutica no notificó la concentración en la compra de activos de Novartis